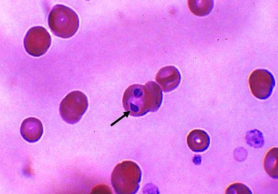
<p>DH - Canine</p><p>IH - Tick</p>

1/12
Looks like no tags are added yet.
Name | Mastery | Learn | Test | Matching | Spaced | Call with Kai |
|---|
No analytics yet
Send a link to your students to track their progress
Trophozoite
Moving form
Oocyst
Fertilized egg that is shed in feces
Sporozoite
Motile, infective form
Flagellum
Long whiplike appendage
Flagellates
Possess at least 1 flagellum in their trophozoite form
Amoebae
Move via pseudopodia (false feet)
Ciliates
Covered in cilia - tiny short hairs that allow movement
Giardia
Tritrichomonas foetus
DH - Bulls, Cows
STD

tritrichomonosis
Toxoplasma gondii
DH - Cats
IH - Anything

Cryptosporidium
DH - Calves
Canine, feline, bovine, ovine, swine, avians, guinea pigs, snakes and mice - these are not as common

Babesia canis
DH - Canine
IH - Tick